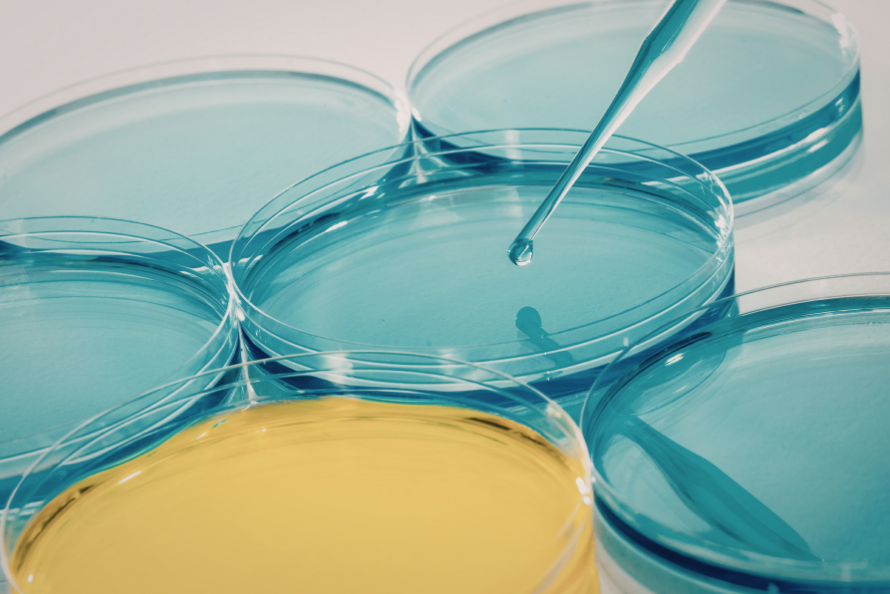

Join us March 19, 2026 to explore how regulation, industry leadership, and trusted data are shaping the future of life science operations across Europe and beyond.

Explore highlights from our previous summits and special events. Many include on-demand recordings, resources, and follow-up links.
2025 Carbon Impact Report
Leading through change
This event featured innovative panelists discussing how to lead on climate performance amid ESG market pushback, and unveiled our annual Carbon Impact Report.
Global Summit 2025
Rising to the challenge
Join the global scientific community at our flagship event focused on sustainability, innovation, and impact in science.
Europe Summit 2025
Scalable solutions for wider impact
This event featured European case studies and speakers from across the sector, including academic researchers, industry professionals, and sustainability experts.
Global Summit 2024
Raising the bar
This event addressed the urgency and opportunity facing science today, highlighting transparency, third-party verification, and strategies for navigating evolving regulations.
Global Summit 2023
Engagement + Impact
This event explored practical tools and strategies for engaging scientists in a process that lead to lasting and measurable impact.
Europe Summit 2023
From inspiration to implementation
This event convened the best green labs initiatives from the continent, providing three main perspectives on sustainability challenges and efforts — industry, academia, and healthcare systems.
Global Summit 2022
Community + Collaboration
This event brought together hundreds of leading voices in sustainable science virtually to connect, collaborate and set our community on a shared trajectory of global impact.
Europe Summit 2022
Zero carbon leadership in life science
This event featured a keynote from Dr. Una FitzGerald, case studies from My Green Lab Certified labs in Europe, ACT Label innovations from manufacturers, and a collaborative workshop for the European green lab community.
Global Summit 2021
Vision + Action
This event was shaped by My Green Lab’s bold new VISION: a world where all science is conducted in a way that benefits the health and well-being of people and our planet.
Global Summit 2020
Reaching new heights
This event brought together members of the lab sustainability community in thoughtful conversation about how we together can accelerate the adoption of green lab practices worldwide.
Register to view the recordings
Don’t miss this year’s Summit recordings, featuring expert speakers, breakout sessions, and global collaboration on the future of green labs.